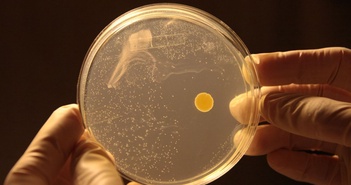

Tin tức về "không khí"

VOV.VN - Hai trong số các thiết bị gia dụng mà nhiều người quan tâm để tạo không gian sống thoải mái ...

VOV.VN - Điều hòa không khí và máy tạo độ ẩm là hai trong số những thiết bị gia dụng mà nhiều người ...

VOV.VN - Máy lọc không khí được xem là lựa chọn được nhiều người dùng quan tâm nhằm đảm bảo sức khỏe ...

Một nghiên cứu mới cho thấy các sản phẩm có hương thơm có thể gây ô nhiễm không khí trong nhà ngang ...

TPO - Nghiên cứu về mật độ vi nhựa trong không khí ở khu vực bãi rác Phước Hiệp, TPHCM cho thấy tốc ...

Các mức độ ô nhiễm không khí có những ảnh hưởng khác nhau đến sức khỏe của từng nhóm người, lứa tuổi ...

Thông tin từ 27 nghiên cứu của các nhà khoa học Anh cho thấy mối liên hệ đáng lo ngại giữa ô nhiễm k ...

Bước đột phá mới nhất trong công nghệ thực phẩm là Solein, một loại thực phẩm trông giống như bột mà ...

Bước đột phá mới nhất trong công nghệ thực phẩm là Solein, một loại thực phẩm trông giống như bột mà ...

Các app thời tiết hiển thị kết hợp nhiệt độ và độ ẩm về mức nhiệt độ cảm nhận. Ngay cả khi nhiệt độ ...
Các nhà khoa học Australia đã phân lập thành công một loại enzyme từ vi khuẩn đất phổ biến có khả nă ...